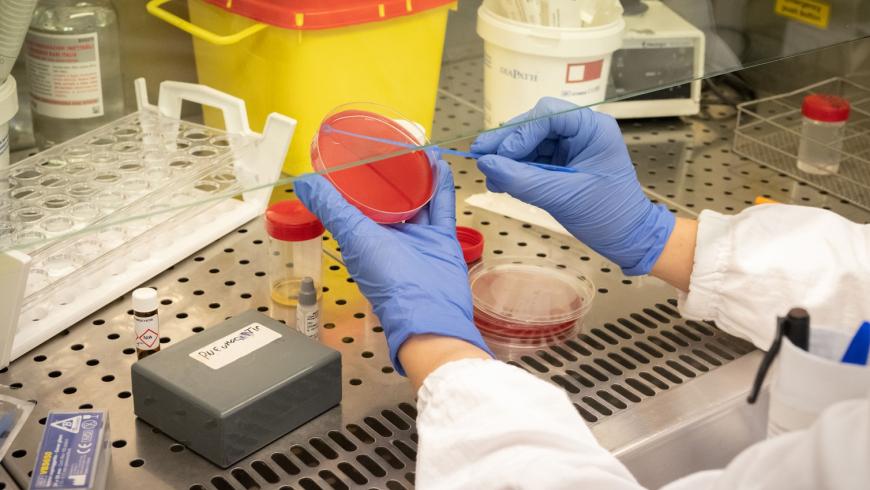
Laboratori di ricerca

- Dipartimento
- Dipartimento Attività Integrate Ricerca e Innovazione
Laboratori di ricerca: tecnologia al servizio della sanità
- Data di pubblicazione
- 20 Ottobre 2022
L’evento online il 20 ottobre su network, integrazione e ricerca a supporto della clinica
Appuntamento il 20 ottobre alle ore 14.30 con un evento online dedicato all’applicazione della tecnologia in sanità, facendo il punto sulle attività di ricerca in questo ambito condotte dai laboratori integrati tra l’Azienda Ospedaliera di Alessandria e l’Università del Piemonte Orientale.
Ad aprire il pomeriggio l’intervento di Marianna Semprini - Research Team Leader Rehab Technologies Lab dell’Istituto Italiano di Tecnologia (IIT), ente partner della SSD Laboratori di Ricerca, coordinata da Annalisa Roveta e afferente al Dipartimento Attività Integrate Ricerca e Innovazione, diretto da Antonio Maconi. Al fine di favorire lo sviluppo traslazionale e l’implementazione clinica, infatti, la struttura ha stipulato specifici accordi di collaborazione con laboratori di ricerca avanzata, tra cui l’IIT che mette la tecnologia al servizio della salute, l’Istituto Ramazzini e il Politecnico di Torino.
La sessione centrale è dedicata al punto di forza dei laboratori di ricerca, ovvero la forte sinergia e integrazione con il Dipartimento di Scienze e Innovazione Tecnologica che permette ai ricercatori di disporre di attrezzature e tecnologie all’avanguardia per sviluppare una ricerca di base e una ricerca traslazionale, oltre che una ricerca applicativo-tecnologica a carattere biomedico e informatico. Sarà l’occasione per illustrare l’ultimo laboratorio integrato istituzionalizzato, ovvero quello dedicato alla ricerca amianti, presentato da Leonardo Marchese, Direttore del DiSIT e Project Leader dei Laboratori di ricerca, che ben si inserisce all’interno del percorso che l’Ospedale di Alessandria insieme all’ASL AL sta compiendo per il riconoscimento a IRCCS per le patologie ambientali e asbesto-correlate.
L’evento terminerà con una carrellata di alcuni laboratori aziendali, le cui attività non sono ancora state presentate pubblicamente. In particolare si toccherà il tema del sequenziamento affrontato all’interno della Microbiologia, del radiofarmaco prodotto nella Medicina Nucleare e del ruolo degli assetti linfocitari nei pazienti ospedalizzati affetti da Covid indagato dal Laboratorio Analisi.
L’iniziativa di approfondimento scientifico ha quindi il triplice obiettivo di dare risalto alla rete nazionale in cui i Laboratori sono inseriti, riaffermare la collaborazione con l’UPO e illustrare il lavoro di ricerca del Dipartimento dei Servizi aziendale a supporto degli studi clinici per l’analisi dei pazienti inseriti nelle sperimentazioni attivate.
- Link di approfondimento
- Collegati all'evento